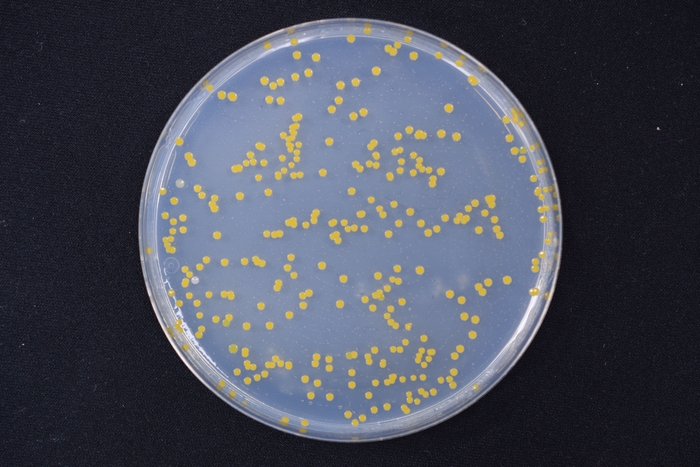
鶏肉_シャーレ画像(2日目)
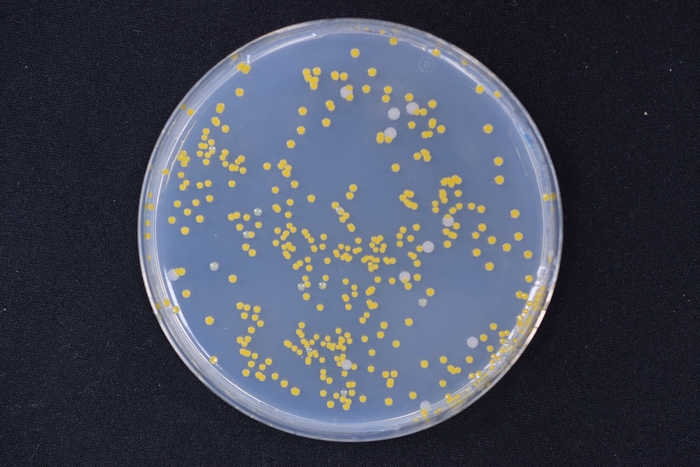
鶏肉_シャーレ画像(4日目)
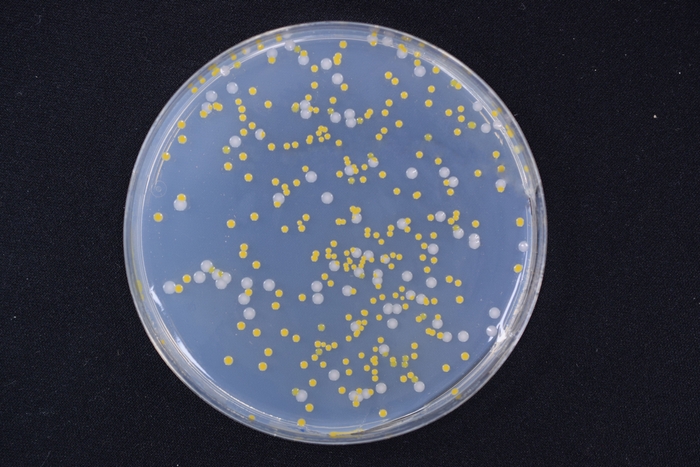
鶏肉_シャーレ画像(6日目)
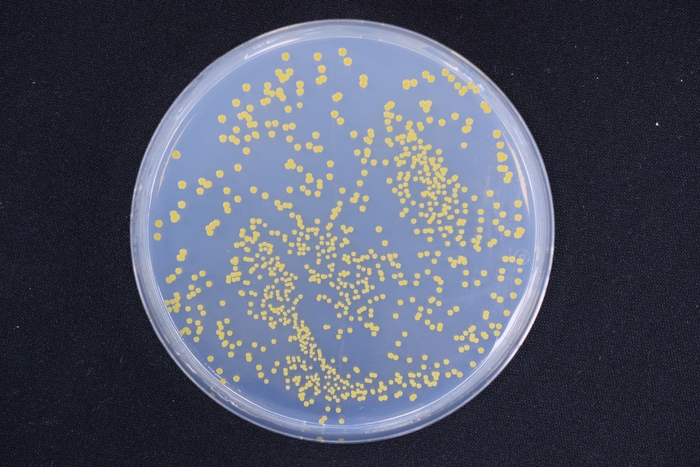
鶏肉_シャーレ画像(7日目)

梅雨時期の「作りおき」は食中毒リスクが?! 冷蔵庫保管で見た目に変化がなくても、食中毒レベルの菌が存在
20代~40代の働く主婦1,000名にアンケート調査。 その結果から「食中毒」対策の盲点を発見!
ジョンソン株式会社(本社:横浜市/社長:鷲津 雅広)は、特に梅雨の時期に気になる、一般家庭内での「作りおき」の食中毒リスクに関する実証実験を行いました。衛生微生物研究センター 主席研究員 李 新一氏監修のもと、一般家庭内での「作りおき」シーンを想定し、作りおき料理中の菌繁殖を検証。また、併せて20代~40代の働く主婦1,000名を対象に、食中毒に対するアンケート調査を実施しました。

食中毒が発生するレベルの菌が付着していても、見た目やニオイではわからない?!
今回の検証では、作りおきをする際の調理器具(包丁・まな板・タッパー)に食中毒リスクがある菌(黄色ブドウ球菌)が付着していたケースを想定し、長期保管時の菌の増殖を検証しました。菌が付着した包丁・まな板を用いて、加熱調理した鶏肉を切り分け、タッパーに入れた状態で冷蔵庫で7日間保管しました。その結果、初日には料理に食中毒が発生するレベルの菌が付着しており、その量の菌が7日間付着し続けていても、鶏肉の見た目には変化が見られませんでした。食中毒菌は少量の付着でも食中毒を引き起こす可能性があり、見た目やニオイにはほとんど影響がなくても、注意が必要です。
◇2日目(菌数:180万個/g)

◇4日目(菌数:150万個/g)

◇6日目(菌数:110万個/g)

◇7日目(菌数:190万個/g)

※生菌検査ごとに同じ調理済みの鶏肉を切り分けて検証。
※食中毒リスクがあるレベルの菌量が長期間付着していても、料理の見た目には変化が見られない。
作りおき料理の注意ポイント!包丁・まな板・タッパーに菌が付いているケースが
今回の検証では加熱調理した鶏肉に、菌が付着した調理器具を用いて切り分けたシーンを想定しました。今回のように、加熱調理しても、その食材を菌がついたまな板の上や包丁で切ったり、菌のついたタッパーに保存したりすると、「作りおき」料理に菌が“ついて”しまう可能性があります。たとえまな板・包丁・タッパー等の調理器具を食器用洗剤で洗っても、菌が付着したふきん等で拭いた場合は、同様のリスクがあります。厚生労働省が推奨する食中毒対策にも、調理器具の消毒が挙がっています。
働く主婦1,000名に聞いた梅雨時期の「作りおき」での食中毒対策。調理器具への対策が課題!
20代~40代の働く主婦1,000名を対象にアンケート調査を実施。梅雨時期に「作りおき」を行い、かつ食中毒対策をしていると回答した人に具体的な対策を聞いたところ、「肉、魚、卵などを取り扱うときは、取り扱う前と後に必ず手指を洗う」(73.9%)、「時間が経ちすぎたものは思い切って捨てる」(71.8%)などが上位に入っていました。しかし、まな板・包丁・タッパー等の調理器具を除菌・殺菌しているという人は10%を切っており、調理器具への対策はまだ浸透していないのが現状です。
調理器具に付着する菌対策!アルコール除菌と煮沸消毒の効果を検証
調理器具に付着した菌の対策として、「アルコール除菌」・「煮沸消毒」の効果を検証しました。その結果、菌が付着した調理器具に対し、アルコール除菌剤をスプレーした場合、煮沸消毒した場合とも、99%以上菌が減少したことが確認できました。特にアルコール除菌剤は、使用前にサッとスプレーするだけでよいので、手軽に除菌ができ、便利です。
◇アルコール除菌剤は“使用直前”“乾いた状態”が効果的
食中毒対策としてアルコール除菌をしている人に使用シーンを聞いたところ、「料理後、調理器具を洗った後に吹きかける(器具が乾いた状態)」が42.5%、「料理後、調理器具を洗った後に吹きかける(器具が濡れた状態)」が28.8%と、料理後に使用する人が多い結果でした。
一方で、衛生微生物研究センター 主席研究員 李 新一氏によると、使用後から次に調理するまで時間が空く場合、意図しない形で調理器具に菌が付着する場合もあるため、使用直前にも除菌を行う方がより効果的ということです。さらに、濡れた状態でアルコール除菌剤を使用すると、アルコールが水分で薄まる可能性があり、除菌効果が低くなる恐れがあります。乾いた状態で吹きかけることで、アルコール濃度の高い状態が保たれ、より除菌効果を発揮します。
アルコール除菌剤を食中毒対策として使用する際には、“使用直前”に“調理器具が乾いた状態”で吹き付けるのが最も効果的です。
監修者プロフィール
衛生微生物研究センター 主席研究員 李 新一(り しんいち)
微生物による生活被害を防ぐため、生活環境における微生物分布の解析など、各企業との共同研究を通じて、日夜調査研究を行っている。
監修者コメント
加熱調理で除菌した料理も、汚染された調理器具に触れると、再度細菌が付着し、食中毒リスクが高まってしまいます。
調理器具に細菌が付着しているかどうかは肉眼で判断できないため、調理器具は適宜アルコールや熱湯などの適切な方法で除菌し、食中毒リスクを高めないように心がけましょう。
検証内容
・検証1:作りおきを想定した生菌数測定試験
鶏肉(むね肉)両面をフライパンでよく焼き、包丁、まな板を使って切り分け、タッパーに入れて6℃で保管した。その後、保管時・2日目・4日目・6日目・7日目に生菌数を測定。調理・保管に用いた包丁、まな板、タッパーは黄色ブドウ球菌が付着したものを使用。
・検証2:調理器具の生菌数測定試験
包丁、まな板、タッパーを食器用洗剤で洗った後、肉片、魚片、野菜くずを含んだ汚染水に浸漬させた後、水道水で軽く洗い流したふきんでふき取り、30℃、相対湿度80%で培養した。培養直後、それをアルコール除菌したものの生菌数を検証。
◇調査概要について
調査方法 :インターネットリサーチ
実施期間 :2018年5月25日(金)~2018年5月27日(日)
調査対象者属性:20-40代の働く主婦
調査対象居住地:全国
回答数 :1,000名
◇ジョンソン株式会社について
ジョンソン株式会社( http://www.johnson.co.jp/ )は、住居用洗剤・消臭芳香剤・殺虫剤・食品保存用品などの世界的メーカーである S.C. Johnson and Son, Inc.(米国ウイスコンシン州ラシーン、 http://www.scjohnson.com/ )の関連会社として、1962年に創業いたしました。日本市場で得た経験と、グローバル企業の強みを生かし、日本の市場と消費者から信頼を得られる革新的な製品の導入に注力しています。代表的なブランドとしては、カビ取り剤「カビキラー」、住居用クリーナー「スクラビングバブル」、消臭芳香剤「グレード」、排水パイプクリーナー「パイプユニッシュ」、風呂釜洗浄剤「ジャバ」、虫よけ剤「スキンガード」、台所用廃油処理剤「テンプル」、シューケア製品「KIWI」などがあります。

